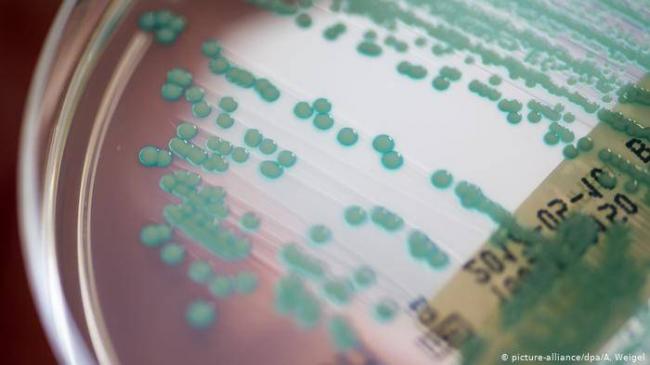
Как наука борется с бактериями, устойчивыми к антибиотикам — российская газета

Как их правильно употреблять
Продукты, обогащённые полезными микроорганизмами, обязательно должны присутствовать в рационе питания.
Каждый день рекомендуется пить не менее 1 йогурта (100-150 мл) и (или) 200 мл кефира. В качестве альтернативы могут выступать напитки на основе чайного гриба и квашенная капуста.
Подобный вариант «лечения» подходит только здоровым лицам с целью профилактики, а также людям, имеющим незначительные нарушения здоровья.
При тяжёлом дисбактериозе, обусловленном различными причинами, продукты питания существенную роль в восстановлении нормальной микрофлоры сыграть не смогут. Рекомендуется принимать различные медикаментозные пробиотики (Лактобактерин, Линекс, Хилак-Форте и т.п.) согласно предписаниям врача.
Ни в коем случае нельзя начинать использование лекарственных средств самостоятельно, так как они могут быть небезопасны.
Врачи подчеркивают, что бактерии играют двойственную роль в здоровье желудка. С одной стороны, некоторые из них необходимы для нормального пищеварения и поддержания баланса микрофлоры. Например, полезные бактерии помогают расщеплять пищу и синтезировать витамины. Однако, с другой стороны, патогенные бактерии могут вызывать серьезные заболевания. Инфекции, вызванные Helicobacter pylori, могут привести к гастриту, язвам и даже раку желудка. Врачи предупреждают, что неправильное питание, стресс и злоупотребление антибиотиками могут нарушить баланс микрофлоры, способствуя размножению вредных бактерий. Поэтому важно следить за своим рационом и обращаться к специалистам при первых симптомах дискомфорта.

Лечебные мероприятия
Комплекс лечебных мер можно разделить на 2 этапа, каждый из которых преследует определенную цель.
Антибактериальный этап по уничтожению хеликобактер в желудке предполагает использование нескольких групп препаратов для борьбы с бактерией:
- антибиотики: тетрациклин, амоксициллин, кларитромицин и другие;
- препараты, содержащие висмут;
- антациды.
Назначается антибиотик, убивающий бактерию в пробах от больного. Препараты висмута не имеют активности против бактериальной флоры. Их эффективность доказана только в отношении хеликобактер из-за ее индивидуальных особенностей. Антациды применяются для предотвращения самопереваривания желудком собственных тканей, образуя на поверхности слизистой бактериальную язву или эрозию.
Такая схема эффективна для лечения легких случаев бактериального воспаления или терапии неглубоких язв желудка. Запущенные случаи язвы или эрозии с угрозой прободения не дают времени на выполнение диагностических тестов и применение монотерапии. Используется стандартная методика с вовлечением в процесс лечения нескольких мощных антибиотиков.
- Тритерапия включает антацид и 2 антибиотика.
- Квадротерапия дополнительно имеет в составе препараты висмута.
Восстановительный этап необходим для качественного рубцевания изъязвленных участков стенок желудка. Еще он включает меры по профилактике рецидива появления хеликобактер на прежнем месте:
- Продолжение приема лекарств, снижающих выработку кислоты в желудке.
- Строгая диета.
- Препараты обволакивающего действия: викаир, алмагель, викалин, крахмал в виде густого киселя.
Диета, вызывающая и стимулирующая в организме силы для восстановления, сопровождает оба этапа лечения. Она должна щадить желудок. Ведь он активно участвует в пищеварении. Поэтому необходимо строго соблюдать правила питания. Их немного:
- Объем порции – пригоршня пациента.
- Питаться через каждые 2–3 часа.
- Исключить приправы (соль, перец, специи).
- Каши готовить на воде до слизистого состояния.
- Консервы строго воспрещены.
- Исключаются все напитки с насыщенным вкусом и цветом: крепкий чай, соки, кофе, газированные напитки.
- Табак и алкоголь – их употребление запрещается.
- Еда должна быть оптимальной температуры (20–38C).
Это позволит желудку восстановить нарушенную хеликобактер слизистую оболочку. Длительность диеты будет зависеть от тяжести перенесенного заболевания и скорости рубцевания эрозий или язв.
Снижение массы тела
Живые бактерии продуцируют массивный объём липазы – особого фермента, который замедляет всасывание жиров, употреблённых с пищей.
В результате жиры выводятся из организма, а не откладываются в жировых депо. Данное свойство, по мнению японских учёных, особенно полезно для лиц, склонных к ожирению.
Одно из исследований обнаружило, что приём лактобактерий (Lactobacillus gasseri), даже в низких дозах, приводит к снижению окружности живота на 8,5%.
Примечательно, что пробиотики высоко эффективны в отношении абдоминального ожирения (висцерального жира), что положительно сказывается на работе внутренних органов.
Пробиотики можно употреблять с целью снижения массы тела, а также для профилактики развития ожирения при неправильном питании.
Бактерии играют двойственную роль в нашем организме, особенно в желудочно-кишечном тракте. С одной стороны, некоторые из них необходимы для нормального пищеварения и усвоения питательных веществ. Например, полезные бактерии, такие как лактобактерии, помогают поддерживать баланс микрофлоры и защищают от патогенных микроорганизмов. С другой стороны, некоторые бактерии могут быть опасны. Хеликобактер пилори, например, ассоциируется с развитием гастритов и язвенной болезни. Инфекции, вызванные патогенными бактериями, могут привести к серьезным расстройствам, таким как диарея, рвота и даже перитонит. Поэтому важно поддерживать здоровье желудка, следя за питанием и соблюдая правила гигиены, чтобы минимизировать риск заражения опасными микроорганизмами.

Улучшение психического здоровья
Повышение содержания полезных микроорганизмов в кишечнике способствует нормализации настроения и профилактике психических расстройств. Особенности воздействия на центральную нервную систему до конца не изучены.
Эксперименты, проведённые немецкими и итальянскими учёными, обнаружили, что включение лактобактерий в рацион на протяжении нескольких дней улучшает общий эмоциональный фон, способствует профилактике депрессии, тревоги. Отмечено повышение способности воспринимать и запоминать информацию.
Иранские исследования доказали схожие результаты: пробиотики снижают проявления депрессии. Также они угнетают процессы перекисного окисления липидов, подавляют продукцию С-реактивного белка, тем самым способствуют уменьшению воспалительных изменений как в стенке кишечника, так и во всём организме.
Рекомендуется использовать пробиотики в период сильных эмоциональных нагрузок для профилактики различных сбоев со стороны центральной нервной системы.
Причины возникновения инфекции
Если бактерия есть в организме, то попасть в пищеварительный тракт она могла одним из четырех способов:
- после использования предметов личной гигиены, которые принадлежат другим людям;
- через плохо вымытые столовые приборы и посуду, игрушки, поильники и пустышки;
- во время поцелуя и интимной близости (в слюне и слизистых выделениях есть микроорганизмы);
- через оборудование в больнице (если им обследовали больного и не провели должную обработку).
Продукты жизнедеятельности зараженных людей тоже представляют опасность: в кале и рвотных массах хеликобактер пилори некоторое время остается активной. Есть только одно направление, откуда бактерию ждать не приходится, – по открытому воздуху она не передается. Причины просты: организм паразита при прямом контакте с O2 погибает, так как является типичным анаэробом.
Схема заражения такова:
Слизистая желудка ослабляется постепенно, чем дольше микроорганизмы на нее воздействуют, тем выше риск развития еще более опасного заболевания: рака двенадцатиперстной кишки или желудка. Если бактерия хеликобактер пилори есть в организме, она может не сразу дать знать о себе. Толчком для бурного роста и развития может послужить пережитый стресс, смена образа жизни, ослабление иммунитета после болезни, деструктивные привычки. В этом случае дремлющий микроорганизм просыпается и развивает бурную деятельность.

Как дисбактериоз отражается на внешности?
Оказывается, прием пре- и пробиотиков может решить и некоторые «внешние» проблемы: угревая сыпь, перхоть и даже облысение. Ведь свои микробы есть и на коже. Доказано, что состав кишечной микрофлоры и микробов, обитающих на коже головы и лица, зависит друг от друга.
Загадкой до сих пор остается только то, что первично: угревая сыпь или дисбактериоз кишечника?
Однако в настоящее время пре- и пробиотики эффективно используются для лечения кожных заболеваний.
В последние годы многие косметические компании стали разрабатывать косметику, состоящую из пробиотиков. Среди заявленных свойств — не только решение проблемы акне, но и замедление старения кожи, противоаллергическое и противовоспалительное действия.
Лечение от хеликобактера при хроническом гастрите?
У больных хроническим гастритом хеликобактер обнаруживают в 65—80% случаев. Что уже нарушает .
Но важнее то, что при изучении микробиоценоза желудка у больных с гастритом было установлено, что в 82,1±7,2% случаев в слизистой оболочке желудка обнаруживают, помимо хеликобактера, 55(!) видов патогенных и условно-патогенных бактерий.
В том числе, например:
- стрептококки (30,9±6,2%),
- стафилококки (16,4±5%),
- энтеробактерии (10,9±4,2%),
- грибы рода Candida (10,9±3,9%)
- коринебактерии (7,3±3,5%).
Кстати, при ОСТРОМ гастрите хеликобактер был выявлен всего в 7,1±4,8% случаев, причем всегда в комплексе с другими бактериями.
При изучении свойств выделенной из слизистой оболочки желудка бактериальной флоры:
- в 36,3±6,5% случаев были выявлены природные или приобретенные в процессе адаптации к агрессивной желудочной среде патогенные свойства,
- в 45,5±6,7% — резистентность (устойчивость) к различным антибактериальным препаратам (АБП).
- признаки патогенности установлены у 56,4±6,7% выделенных бактерий.
- вся выявленная микрофлора обладала , а большинство бактерий — (в отличие от хеликобактера) и патогенными свойствами.
Вывод тут такой – вместе с хеликобактером (и без него) в желудке есть масса микробов, которые
- гораздо опаснее, чем хеликобактер и
- могут вызывать гастрит сами по себе.
Но почему-то от них не лечат, а лечат от хеликобактера.
Курс назначаемого врачами лечения ведь рассчитан именно на него, его свойства: стойкость и/или нестойкость к применяемым лекарствам. А тем временем, за его «плечами» реальные виновники заболевания – те же стрептококки, стафилококки и прочие вполне себе нормально поживают дальше.
Скорее всего, именно этим объясняется то, что в большинстве случаев, после лечения от хеликобактера в анализах его нет, а больному лучше не становится. Часто даже ещё хуже. Почему хуже – подробно объясню далее.
Отвлечемся на минуточку от гастрита. Ниже целый перечень попыток натянуть сову на глобус, то есть связать хеликобактер с разными болезнями.
Что делают и о чем тут речь? Есть какая-нибудь болезнь. Берут у пациентов анализ на хеликобактер. Есть? Ура! Значит причина в нем. Ну, то есть, вы понимаете, что таким методом можно попытаться привязать к хеликобактеру любую болезнь. Зачем и для чего это делают — разберемся далее.
Приемы нетрадиционной медицины
В арсенале народных средств имеются рецепты для избавления от хеликобактер. В те времена люди тоже «мучились желудком». Их мучения знакомы современным людям.
- Слизь отвара семени льна, настоянная 2 часа и профильтрованная, успокоит боли и защитит язву от кислоты желудка. Пить по 1 ст. ложке до еды.
- Несколько часов настоянная в кипятке смесь разнотравья (ромашка, чистотел, тысячелистник и зверобой – их насыпать поровну), взятая в пропорции 4 ст. л. на литр воды, должна приниматься мелкими глотками до еды. На прием достаточно четверти стакана.
- Давно известный народной медицине прополис в виде спиртовой настойки (чайную ложку на полстакана воды) пить за час до еды для избавления от бактерии.
- Сок из картофеля (полстакана), выпитый перед едой, успокоит желудочную язву или гастрит.
Народные секреты в современное время не должны рассматриваться как лекарство. Времена другие – теперь они стали помощниками новых методов и способов лечения. Желудок, пораженный хеликобактер, требует незамедлительного начала терапии на любой стадии болезни. Слишком грозны последствия отсрочки: язва, перфорация, рак. Их проще избежать, чем лечить.
Похожие и рекомендуемые вопросы
Что это? Как лечить? Что дополнительно сдать? Пришли анализы фемофлор. К врачу только…
Бак. Посев сделали всего вместе После лечения вагинита гинеколог взяла мазок из влагалища…
Здравствуйте, помогите пожалуйста расшифровать Фемофлор 16 и Бак посев Помогите пожалуйста…
Вагиноз и гардренелла Хотела к вам обратиться с таким вопросом так как не знаю уже…
Фемофлор и общий мазок на флору. Помогите разобраться с результатами! Сдавала в одной…
Плоский эпителий в мазке Подскажите пожалуйста является ли требованием к лечению наличие…
Жжение и гнойные выделения из влагалища, нет точного диагноза Пытаюсь вылечиться уже…
Есть ли у меня впч если анализ пцр отрицательный Многоуважаемая Елена Викторовна….
Запах и выделения при нормальных анализах Меня беспокоит легкий неприятный запах и…
Баквагиноз На протяжении 3 — х лет беспокоит жжение внутри и снаружи половых органов…
Больше нет сил, помогите умоляю Помогите пожалуйста, в 2016 году я прошла длительные…
Уреаплазма и гарднерелла при планировании Б Планируем беременность. Месяцев 5 был…
Расшифруйте ответы анализа Вот сегодня пришли анализы Фемофлор скрин. Подскажите что…
Ярко-белые выделения на нижнем белье На нижнем белье появляются немного ярко-белых…
Расшифровка бак посева мазка Помогите пожалуйста расшифровать анализ. Прикрепляю фото….
Фемофлор 16 расшифровка Помогите пожалуйста расшифровать анализ Фемофлор 16, сильно…
Нужно ли лечить? Подскажите пожалуйста! При сдаче анализа фемофлор скрин обнаружились:…
Лечение обостряет жжение в мочевом пузыре Татьяна Алексанлровна! Столкнулась с проблемой…
Зуд и жжение во влагадище Уже пол года мучит зуд и жжение во влагалище в районе половых…
Зуд, жжение и пощипывание после мочеиспускания, что делать? С ноября 2015 года начали…
Новости на тему: бактерии при антибиотиках
Читать дальше
Обнаружен механизм распространения устойчивости бактерий к антибиотикам
Ученые обнаружили структуру ключевого компонента бактерий, играющего важную роль при таких заболеваниях, как коклюш, язвенная болезнь желудка и болезнь легионеров. Это позволило более четко понять, каким образом гены, обусловливающие резистентность бактерий к антибиотикам, передаются от одного микроорганизма другому
Читать дальше
Из пушки по воробьям, или убей меня мой антибиотик
В то время как ВОЗ предупреждает жителей планеты о новом побочном эффекте бесконтрольного приема антибиотиков, неожиданно выяснилось, что жители Австралии лечат такими лекарствами едва ли не все болезни. Это способствует появлению супербактерий.
Читать дальше
Антибиотики ухудшают качество спермы
Ученые считают, что неоправданно широкое распространение и применение препаратов группы антибиотиков приводит к развитию лекарственной устойчивости у штаммов опасных бактерий. Но антибиотики могут наносить и прямой вред организму человека.
Читать дальше
Тараканы и саранча станут помощниками в создании новых антибиотиков
Все чаще появляются сведения о том, что медики сталкиваются со штаммами возбудителей опасных инфекционных заболеваний, которые проявляют практически абсолютную устойчивость к существующим антибиотикам, даже самым новым. Усилия ученых, создающих все более современные (и все более дорогие) препараты, и ответные «ходы» микроорганизмов, которые в полном соответствии с теорией борьбы за выживание приспосабливаются к лекарствам, уже давно наминает известное заочное сражение создателей танковой брони и конструкторов противотанковых пушек – конца ему не видно. Но на днях появились сообщения, что очередной (пусть и временный) прорыв в создании антибиотиков нового поколения возможен – и неожиданными помощниками человека в этом станут его давние злейшие враги: тараканы и саранча.
Читать дальше
Дезинфектанты развивают у бактерий лекарственную устойчивость
Растворы для дезинфекции используют для удаления бактерий. При использовании этих растворов в недостаточных концентрациях бактерии могут к ним приспособиться
Читать дальше
Мед лечит лучше антибиотика
Мед оказался даже более эффективен против некоторых бактерий, чем антибиотик, не говоря уже о том, что он просто вкуснее и безопаснее лекарств
Читать дальше
Почему антибиотики не действуют на бактерии?
Ученые определили роль двух протеинов, которые обуславливают нечувствительность болезнетворных бактерий к определенным антибиотикам
Читать дальше
Анализ крови определит, нужны ли антибиотики при простуде
Причиной большинства простудных заболеваний являются всевозможные вирусы, однако более 70% больных простудой стремятся принимать антибиотики, бесполезные при вирусной инфекции. Выявить точную причину недомогания поможет новый метод анализа крови.
Читать дальше
В Калифорнии борьбу с устойчивостью бактерий к антибиотикам начали с животных
Власти штата Калифорния сочли появление антибиотикоустойчивых штаммов болезнетворных микроорганизмов серьезной угрозой здоровью местных жителей. Для уменьшения опасности принят закон, резко ограничивающий использование лекарств в ветеринарии.
Что такое пробиотики?
Знали ли вы о том, что медицинское название полезных бактерий – пробиотики? Слово это берет свое начало с греческого языка, где «про» означает «для» и «биотик» — живой. Если полностью расшифровать слова, то:
Пробиотик в пер. с греч. – тот, который в интересах жизни.
Так что же такое пробиотики? Это продукты, которые относятся к молочнокислым. Фактически, это живые бактерии, которые могут полноценно существовать, размножаться и оказывать пользу только в условиях кислой среды. Вот почему практически на каждом йогурте, кефире и ряженке вы можете найти надпись – содержат такое-то количество полезных бактерий (или же бифидобактерий).
Здесь сразу же можно развенчать популярный миф о том, что чтобы наполнить свой желудок и организм в целом полезными бактериями, необходимо обязательно приобрести дорогостоящий йогурт в виде Актимель, Эко-йогурты и т.д. Вы только лишний раз будете переплачивать деньги, оно того не стоит!
Полезные бактерии содержатся в любом кисломолочном продукте, представленном в магазине или же на рынке. И количество этих бактерий будет ровно таким же, как в дорогостоящем разрекламированном йогурте.
Небольшое количество полезных бактерий содержится в хлебе, в злаках, пиве и квасе. Но, все же, полезнее насыщать свой организм именно бифидобактериями, которые находятся в кисло-молочных продуктах.
Популярные статьи на тему: бактерии при антибиотиках
Читать дальше
Инфекционные заболевания
Конгресс «Лекарства и жизнь» «Новые» фторхинолоны и резистентность к антибиотикам
Предлагаем вашему вниманию доклад профессора С. В. Сидоренко (Государственный научный центр по антибиотикам, Москва, РФ) в котором рассмотрена важнейшая проблема терапии инфекционных заболеваний — формирование лекарственной…
Читать дальше
Инфекционные заболевания
Неантибактериальные эффекты антибиотиков
Традиционно значение антибиотиков обсуждается в контексте их непосредственного противомикробного действия.
Читать дальше
Инфекционные заболевания
Спирамицин: вторая молодость макролидного антибиотика
Макролидные антибиотики около 50 лет применяются в клинической практике. Первый препарат этого класса – эритромицин – был внедрен в практику в 1952 г., спустя три года появился еще один препарат – спирамицин (Ровамицин).
Читать дальше
Инфекционные заболевания
Дифференцированное применение карбапенемов
Карбапенемы – антибиотики сверхширокого спектра действия, проявляющие активность в отношении грамположительных и грамотрицательных микроорганизмов – как аэробных, так и анаэробных.
Читать дальше
Инфекционные заболевания
Антибиотики: жизнь против жизни
Хотя мир узнал об антибиотиках чуть более 70 лет назад, их открытие имело огромное значение. Например, считается, что именно эта группа препаратов позволила продлить жизнь человека в среднем на 20 лет.
Читать дальше
Аллергия
На какие лекарства бывает аллергия
Лекарственная аллергия подразумевает развитие различных реакций не только на препараты, но и на вещества, которые применяются при диагностических процедурах.
Читать дальше
Инфекционные заболевания
Проблемы рациональной антибиотикотерапии в педиатрии
Проблемы антибактериальной терапии являются чрезвычайно актуальными по ряду причин: во-первых, антибиотики – это наиболее широко используемые лекарственные средства, во-вторых, только от 25 до 55% больных получают адекватное лечение антибиотиками.
Читать дальше
Акушерство, гинекология, репродуктивная медицина
Моксифлоксацин в лечении урогенитальных инфекций
Проблема высокой заболеваемости инфекциями, передаваемыми половым путем, продолжает оставаться актуальной во всем мире. При этом за последние 30 лет наши представления об этой патологии претерпели существенные изменения.
Читать дальше
Пульмонология, фтизиатрия
Амоксициллин/клавуланат в лечении инфекций дыхательных путей: 25-летний путь инновационного препарата
Амоксициллин/клавуланат (Аугментин) доступен уже более 20 лет и продолжает быть одним из самых назначаемых в клинике антибиотиков, в том числе при лечении инфекций дыхательных путей.
Профилактика сердечно-сосудистых заболеваний
Действие на сердечно-сосудистую систему многогранно. Например, отдельные пробиотики способны продуцировать молочную кислоту, которая разрушает желчь в кишечнике. В результате желчь не всасывается обратно и выводится из организма. Данная особенность позволяет снизить концентрацию атерогенного холестерина в плазме крови.
Обнаружено, что употребление йогурта, обогащённого живыми микроорганизмами, на протяжении 2 месяцев способствует снижению общего холестерина на 4%, а липидов с низким удельным весом, которые вызывают развитие атеросклероза, — на 5%.
Пробиотики также эффективны в отношении гипертонии и симптоматических артериальных гипертензий. В ходе регулярного добавления в пищу пробиотиков выявлено снижение артериального давления. При этом, чем выше изначальное повышение АД, тем сильнее выражено их действие.
Пробиотики способны незначительно понижать артериальное давление и предотвращать атеросклероз крупных сосудов, что ведёт к повышению продолжительности жизни за счёт уменьшения частоты встречаемости таких патологий, как ишемическая болезнь сердца и инсульт.
Противоаллергическое действие
Восстановление и поддержание оптимального соотношения между полезными и вредными представителями флоры в просвете кишечника позволяет снизить реактивность местных факторов иммунитета. В результате уменьшается вероятность появления любых сбоев и манифестации аллергических заболеваний.
Финляндские ученые доказали, что у детей, которые получали молоко, обогащённое пробиотиками, снижается тяжесть течения экземы. Действие связано с угнетением выброса медиаторов воспаления на фоне аллергии.
Положительные свойства могут проявлять себя и через плаценту. Например, доказано, что у новорожденных, матери которых во время беременности употребляли пробиотические продукты, частота экзем и других аллергических заболеваний встречалась почти в 5 раз реже.
Пробиотики могут применяться для предотвращения и облегчения течения аллергии.
Лечение и профилактика диареи
Доказано, что диарея – самый частый спутник длительного приема антибиотиков, которые уничтожают полезные бактерии, приводя к активации патогенной флоры и нарушению переваривания пищи. Также диарея встречается при течении инфекционно-воспалительных заболеваний.
В ходе проведения крупного исследования (принимало участие почти 12 000 человек) в США было обнаружено, что при приёме антибиотиков совместно с пробиотиками частота развития диареи у взрослых снижается на 42%, также уменьшается тяжесть её течения.
По данным специалистов Университета Суонси (Великобритания), пробиотики также эффективны в качестве метода вспомогательного лечения кишечных инфекций, сопровождающихся диареей. Они способствуют снижению продолжительности нарушения стула в среднем на 25 часов.
Доказано, что систематическое употребление полезных бактерий снижает частоту встречаемости диареи у путешественников (синдром, обусловленный попаданием в организм штампов микроорганизмов, которые раньше не встречались в рационе человека) на 8%. А риск развития острой диареи, обусловленной различными причинами, понижается на 34%.
При этом защитный эффект характерен для всех штампов лактобактерий. Наиболее эффективными представителями бактерий являются: Lactobacillus rhamnosus, Lactobacillus casei и дрожжи Saccharomyces boulardii.
Пробиотики способствуют снижению выраженности диареи, а также предотвращают её развитие. Рекомендуется употреблять больше продуктов, обогащённых полезными микроорганизмами, при течении инфекционно-воспалительных заболеваний кишечника, а также при дальних путешествиях.
Другие методы диагностики на хеликобактер
На основании того, что микроорганизм вырабатывает уреазу, был разработан дыхательный тест. Этот фермент расщепляет мочевину, а результатом реакции становится образование аммиака и углекислого газа. Эти вещества выделяются при дыхании, их присутствие выявит хелик (уреазный) тест. Безопасность и простота исследования сделали его идеальным методом для диагностики детей и беременных женщин.
Во время проведения гастроскопии врач может провести экспресс-тест, который позволит оценить наличие бактерий и их активность. Параллельно со зрительным исследованием у пациента проводится забор образцов слизистой оболочки желудка. Микроскопические образцы помещают в особую среду. Тест будет положительным, если имеющиеся микроорганизмы начнут вырабатывать уреазу и расщеплять мочевину.
Биопсия позволяет почти полностью исключить ложноположительный ответ, который могут дать другие анализы. Тест делается на основе исследования клеток слизистой, а их забирают с особой аккуратностью, не трогая язвы и эрозии.
Перед сдачей любого анализа от пациента потребуется подготовка. Врач должен рассказать о правильной последовательности действий, которых нужно обязательно придерживаться.
Негативные стороны терапии Helicobacter pylori
Независимо от успешности проводимого медикаментозного лечения на организм пациента приходится большая нагрузка в виде побочных действий препаратов.
Наиболее характерные побочные действия терапии хеликобактер пилори
Влияние на нервную систему:
- головные боли;
- бессонница;
- головокружение и дезориентация;
- состояние беспричинной тревоги, различные страхи;
- кошмары в сновидениях;
- различные психозы, галлюцинации и спутанность сознания.
Реакция ЖКТ:
- тошнота и рвота;
- диарея;
- гастралгия (ощущение повреждения тканей);
- стоматиты;
- холестатическая желтуха;
- псевдомембранозный энтероколит и т.д.
Проявления со стороны органов чувств:
- дисгевзия (изменение вкусовых ощущений);
- шум в ушах, возможна временная потеря слуха.
Кожные проявления:
- сыпь;
- зуд;
- злокачественная эритема.
В процессе лечения схемами «Маастрихт» всегда есть угроза передозировки, и, вполне закономерно, у бактерий вырабатывается устойчивость к используемым лекарствам.
В случае небольшого обсеменения бактериями хеликобактер пилори можно попробовать обойтись народными средствами, без схем эрадикации.
Противопоказания и побочные эффекты
К числу наиболее часто встречающихся противопоказаний относятся:
- Повышенная чувствительность организма к продуктам питания с пробиотиками или к отдельным компонентам препаратов. Аллергические реакции могут быть любыми: от крапивницы до анафилактического шока.
- Непереносимость лактозы, а также дефицит изомальтазы, синдром мальасбсорбции. При подобных отклонениях нарушается усвоение медикаментов и молочных продуктов.
Побочные эффекты, в большинстве случаев, не развиваются. Крайне редко возможно появление следующих симптомов:
- головные боли;
- повышение частоты обострений аллергических заболеваний;
- диспепсические расстройства (повышенное газообразование, запоры).
С особой осторожность необходимо употреблять пробиотики лицам со значительными иммунодепрессивными состояниями (лучевая терапия, ВИЧ-инфекция, туберкулёз). В данном случае даже полезные бактерии могут с лёгкостью проникнуть через барьерные ткани и вызвать сепсис
В этом случае риск и степень вреда несоизмеримо выше, чем возможная польза от их употребления. Следует обязательно предварительно проконсультироваться с врачом!
Трудности в терапии инфекции
Helicobacter pillory – бактерия, поэтому борются с ней лекарственными средствами из группы антибиотиков. Существуют две проблемы, осложняющие их эффективное использование:
- Устойчивость микроба к широкому ряду лекарств. В течение жизни человек употребляет множество антибиотиков для лечения других бактериальных инфекций. В это время «дремлющий» хеликобактер привыкает к действию лекарств и перестает реагировать на их присутствие.
- Труднодоступность бактерии. Она живет во внутренней оболочке органа и в слизи, покрывающей ее. Слизь не имеет кровеносных сосудов, поэтому лекарственными средствами ее насытить сложно. Препарат не может достигнуть своей бактериальной мишени.
Эти проблемы легко преодолеть на начальных этапах развития деятельности хеликобактер. Поздние изменения требуют большого количества времени, и лечить их сложнее.
Терапия заболевания
Медикаментозное лечение хеликобактериоза осуществляется по схемам эрадикации, предложенным на «Маастрихт» различных лет.
Именно «Маастрихт» (Европейская группа по исследованию Helicobacter pylori) подтвердил, что ни одна схема не гарантирует на 100% положительный результат.
Для повышения эффективности были выделены несколько схем, названных «линиями». Предполагается, что первоначально пациента следует лечить по схеме из «первой линии», в случае отсутствия результата применять схему из «второй линии».
Трехкомпонентная «первая линия»
Данная схема признана во всем мире как универсальная и включает в себя:
- ингибитор протонного насоса – снижает выработку соляной кислоты, не назначается детям;
- амоксициллин – кислотоустойчивый антибиотик широкого спектра действия;
- кларитромицин – антибиотик, кислотоустойчивая производная эритромицина.
«Первая линия» принимается не менее 7 дней в рекомендованных дозировках. Эффективность воздействия на организм тройной терапии увеличивается вместе с продолжительностью (до 14 дней) и зависит от уровня обсемененности бактериями хеликобактер пилори и способностью пациента переносить терапию.
Четырехкомпонентная «вторая линия»
При отсутствии эффекта применяется «вторая линия», куда входят:
- стандартная дозировка ингибитора протонного насоса, детям назначают гистаминоблокаторы;
- тетрациклин – бактериостатический антибиотик, подавляет синтез белка клетками микроорганизмов;
- метронидазол – антипротозойный и антибактериальный препарат, ингибирует синтез нуклеиновых кислот бактерий;
- салицилат или субцитат висмута – активный в отношении Helicobacter pylori, формирует нерастворимое покрытие на местах изъязвлений.
«Вторая линия» предусматривает увеличение дозировок и времени приема препаратов – от 10 дней и более до достижения эффекта.
Категории
АллергологАнестезиолог-реаниматологВенерологГастроэнтерологГематологГенетикГинекологГомеопатДерматологДетский гинекологДетский неврологДетский урологДетский хирургДетский эндокринологДиетологИммунологИнфекционистКардиологКосметологЛогопедЛорМаммологМедицинский юристНаркологНевропатологНейрохирургНефрологНутрициологОнкологОнкоурологОртопед-травматологОфтальмологПедиатрПластический хирургПроктологПсихиатрПсихологПульмонологРевматологРентгенологСексолог-АндрологСтоматологТерапевтУрологФармацевтФитотерапевтФлебологХирургЭндокринолог
Аптечные БАДы
Не все любят кисломолочные продукты, но при этом желание наполнить свой организм полезными пробиотиками – остается
Выход есть – обратить внимание на аптечные БАДы, в составе которые содержатся полезные бифидобактерии, энтеробактерии и лактобактерии. Все 3 вида бактерий направлены на нормализацию работы желудочно-кишечного тракта и улучшение самочувствия человека
Итак, первый вид БАДов – монопрепараты, в составе которых содержится всего лишь один вид полезных бифидобактерий:
- Бифидумбактерин;
- Лактобактерин;
- Колибактерин.
Такой вид БАДов рекомендовано использовать при легких расстройствах желудочно-кишечного тракта, а также с целью профилактики заболеваний желудка.
БАДы в виде Бактисубтила, Биоспорина и Споробактерина содержат в себе полезные бактерии, а также дрожжеподобные грибы и споровые бациллы, действие которые направлено на выведение токсинов и ядов даже при тяжелом отравлении, диареи и острой форме дисбактериоза.
Также, при дисбактериозах рекомендовано применять Ацилакт, Бифиформ, Бифилиз, Линекс, а при тяжелой форме пищевого отравления – Профибор и Бифидумбактерин.
В заключении: для нормализации работы желудочно-кишечного тракта, улучшения самочувствия, профилактики дисбактериоза и лечения при отравлениях необходимо использовать пробиотики. Содержатся они в большом количестве в кисломолочных продуктах (йогурты, ряженка, кефир, закваска) и в аптечных БАДах.
Вопрос-ответ
Зачем нужны бактерии в желудке?
Бактерии нашего кишечника питаются клетчаткой и пищевыми волокнами, это сложные углеводы, которые не перерабатываются нашим организмом, но расщепляются бактериями кишечника, которые в результате расщепления вырабатывают масляную кислоту, которой питаются клетки нашего организма и помогает поддерживать многие функции
Какие бактерии поражают желудок?
Хеликобактериоз — инфекционное заболевание, которое вызывает бактерия хеликобактер пилори (Helicobacter pylori). С этим микроорганизмом ассоциируют хронический гастрит, язвенную болезнь желудка и двенадцатиперстной кишки, рак желудка и MALT-лимфому (опухолевое заболевание лимфоидной ткани слизистой оболочки желудка).
Какая самая опасная бактерия?
Clostridium botulinum. Эта бактерия вызывает ботулизм – тяжелое заболевание, поражающее нервную систему человека. Escherichia coli. Salmonella typhi. Vibrio cholerae. Clostridium tetani. Treponema pallidum. Streptococcus. Mycobacterium tuberculosis.
Чем опасны бактерии для организма?
Бактерии могут вызывать заболевание, вырабатывая вредные вещества (токсины), проникая в ткани или комбинируя оба эти способа. Некоторые бактерии могут вызывать воспаление, которое иногда поражает сердце, легкие, нервную систему, почки или желудочно-кишечный тракт.
Советы
СОВЕТ №1
Регулярно проверяйте свое здоровье и проходите обследования у гастроэнтеролога. Это поможет выявить возможные проблемы с желудком и предотвратить развитие заболеваний, связанных с бактериями.
СОВЕТ №2
Соблюдайте правила личной гигиены, особенно перед едой. Тщательное мытье рук поможет снизить риск попадания патогенных бактерий в желудок.
СОВЕТ №3
Обратите внимание на качество пищи. Избегайте употребления сырых или недостаточно термически обработанных продуктов, так как они могут содержать опасные бактерии.
СОВЕТ №4
Поддерживайте здоровый баланс микрофлоры кишечника, включая в рацион пробиотики и пребиотики. Это поможет укрепить иммунитет и снизить риск инфекций, вызванных бактериями.